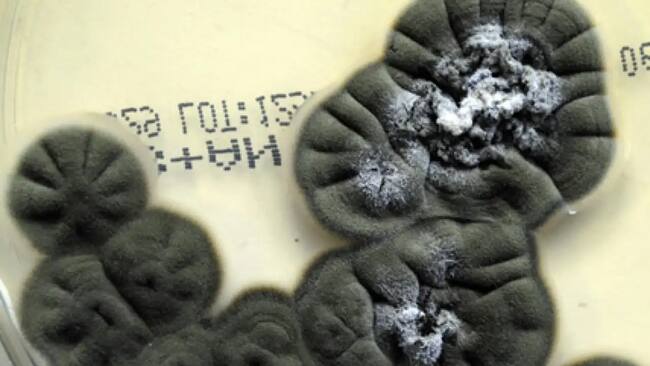
ADN

Repelente natural contra arañas: así puedes prepararlo en casa y mantener los insectos lejos todo el verano
Se trata de una preparación sin químicos agresivos pero con alta eficacia.

Con el verano y el alza de temperaturas en Chile, las arañas buscan refugio en interiores frescos, atraídas por calor y humedad, especialmente en zonas poco transitadas.
Este fenómeno genera incomodidad en muchos hogares, pero existe un método efectivo y natural para mantenerlas alejadas sin químicos agresivos.
Las arañas detectan olores fuertes con sensibilidad extrema, y la menta o el eucalipto las disuade de inmediato de las áreas tratadas.
El aceite esencial de menta o eucalipto no solo repele arañas, sino que neutraliza aromas que atraen a sus presas insectívoras.
Revisa también:
Pasos para preparar y aplicar el repelente
- Prepara la mezcla: Llena un atomizador con agua y añade 10 a 15 gotas de aceite esencial de menta por cada taza de agua. Agrega unas gotas de jabón líquido para emulsionar mejor el aceite.
- Rocía las zonas estratégicas: Aplícalo en esquinas, ventanas, puertas, detrás de muebles y rincones oscuros. Enfócate en ventanas y puertas como principales accesos.
- Reaplica cada semana: El aroma se desvanece con el tiempo, así que repite la aplicación semanalmente o tras limpiar para sostener la barrera.
- Considera otros lugares de entrada: Rocía rejillas de ventilación, espacios de almacenamiento y áreas poco frecuentadas que sirvan de escondite.
Este repelente también ahuyenta otros insectos, deja un aroma fresco y resulta seguro para niños, mascotas y el medio ambiente, a diferencia de aerosoles químicos.
Optar por aceite de menta asegura un hogar libre de arañas de forma sencilla y probada, ideal para disfrutar el verano sin riesgos.
Sigue a ADN.cl en Google Discover
Recibe nuestros contenidos directamente en tu feed.























